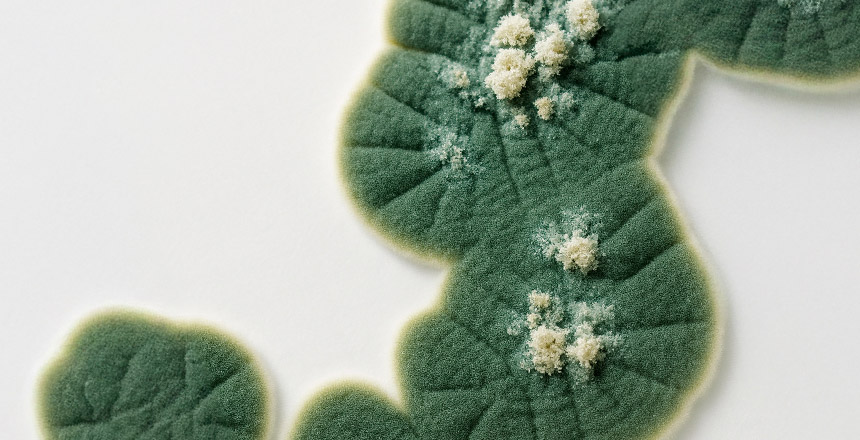
Фото - Аллергия на плесневые грибы и дрожжи: клиническое значение и диагностические возможности ALEX²

Аллергия на плесневые грибы и дрожжи: клиническое значение и диагностические возможности ALEX²
27.10.2025Автор: Елена Шарикадзе
Прогнозируемое количество видов грибов в мире колеблется от 0,6 до 1 миллиона, что делает их одним из самых разнообразных царств живых организмов. Согласно классификации медицинской микологии, грибы, имеющие клиническое значение, делятся на три основные группы: дерматофиты, дрожжи и плесневые грибы.
Дерматофиты вызывают дерматофитию рогового слоя кожи, волос и ногтей, обладая уникальной способностью питаться кератином благодаря продукции кератиназы. Дрожжи представлены одноклеточными, шаровидными грибами, которые размножаются почкованием; наиболее распространенными ассоциированными с ними заболеваниями являются кандидоз (виды Candida) и атопический дерматит (виды Malassezia).
Особое клиническое внимание привлекают плесневые грибы (плесень), которые часто являются этиологическим фактором респираторных заболеваний. Плесень (Alternaria, Aspergillus, Cladosporium, Penicillium и др.) – это вездесущие микроорганизмы, споры которых легко распространяются по воздуху и быстро формируют сенсибилизацию. Эти грибы могут вызывать широкий спектр патологических состояний: от аллергического ринита и астмы до тяжелых осложнений, таких как аллергический бронхолегочный аспергиллез (АБЛА) и гиперчувствительный пневмонит.
По данным международных эпидемиологических исследований, 10–15% пациентов с бронхиальной астмой сенсибилизированы к плесневым грибам, причем распространенность значительно возрастает во влажном климате и при наличии плесени в помещениях. Показано, что сенсибилизация к грибам чаще развивается у лиц, которые уже имеют другую сенсибилизацию или страдают астмой. В частности, Aspergillus fumigatus играет критическую роль у пациентов с тяжелой астмой. К группе повышенного риска также относятся иммуносупрессированные больные, пациенты с тяжелым течением COVID-19, муковисцидозом и хронической обструктивной болезнью легких (ХОБЛ).
Актуальные обзоры (Hurraß J. et al., 2024, Dtsch Arztebl Int, DOI:10.3238/arztebl.m2024. 0018) подчеркивают медицинское значение воздействия плесени и необходимость в современных алгоритмах диагностики, где ключевую роль может играть молекулярный подход, в частности технология ALEX².
Биологическая характеристика плесневых грибов и механизмы их распространения
Плесневые грибы (плесень) составляют большую группу микроскопических грибов, которые активно размножаются и быстро образуют колонии. Их споры легко разносится воздухом, водой или контактным путем и присутствуют практически везде – от помещений до высокогорных регионов. Плесень может расти на любом материале (дерево, стекло, пластик, кафель) при наличии влаги или влажной среды.
Особенности размножения плесневых грибов
1. Бесполое размножение (спорообразование) – самый распространенный способ, при котором многочисленные споры легко распространяются различными путями:
- Конидии – сухие, легкие споры, формирующиеся на конидиеносцах (характерны для Aspergillus, Penicillium)
- Спорангиоспоры – формируются внутри спорангия (характерны для Mucor)
- Фрагментация мицелия – части гиф отламываются и образуют новые колонии
- Хламидоспоры – толстостенные клетки, устойчивые к неблагоприятным условиям
2. Половое размножение происходит в неблагоприятных условиях с образованием зигоспор, аскоспор или базидиоспор (в зависимости от группы грибов). Эти структуры обладают высокой устойчивостью к высыханию, температурным колебаниям и УФ-излучению, обеспечивая генетическое разнообразие и адаптацию к новым условиям.
Быстрое распространение
Споры плесневых грибов чрезвычайно легкие и многочисленные: в 1 м³ воздуха может содержаться тысячи спор. Благодаря этому они быстро заселяют новые субстраты, включая органические остатки, продукты питания и строительные материалы.
Эпидемиология и клиническое значение грибковой сенсибилизации
Аллергия на плесневые грибы (Alternaria, Aspergillus, Cladosporium, Penicillium и др.) и дрожжи (Candida, Malassezia) является серьезным вызовом для современной медицины. Споры грибов легко ингалируются и довольно быстро формируют сенсибилизацию, которая связана не только с развитием аллергического ринита или астмы, но и с тяжелыми осложнениями. Характерной особенностью аллергии на плесень является сезонность симптомов (лето-осень) и возможность круглогодичного течения во влажном климате или при наличии плесени в помещении.
В последние годы эпидемиологические исследования демонстрируют высокую распространенность грибковой сенсибилизации среди пациентов с астмой, причем чаще всего фигурируют роды Aspergillus и Alternaria. В пределах типа Ascomycota несколько родов, включая Aspergillus, Penicillium, Alternaria и Cladosporium, распространены как в помещениях, так и на улице, представляя потенциальную опасность для прогрессирования астмы.
Таблица 1. Связь грибковой сенсибилизации с тяжелой астмой
|
Плесень |
OR |
95% CI |
|
Aspergillus spp. |
2,36 |
1,52–3,66 |
|
A. fumigatus |
2,98 |
1,87–4,74 |
|
Cladosporium spp. |
2,63 |
1,35–5,14 |
|
Penicillium spp. |
1,75 |
1,12–2,73 |
Примечание: OR (Odds Ratio) – отношение шансов, статистический показатель, используемый для оценки силы связи между фактором и результатом. OR=1 означает отсутствие связи, OR>1 – фактор повышает вероятность события, OR<1 – фактор снижает вероятность события.
95% CI (Confidence Interval) – доверительный интервал, диапазон значений, в котором с вероятностью 95% находится истинное значение параметра.
Источник: https://doi.org/10.3389/fpubh.2025.1582643
Как видно из таблицы, сенсибилизация к A. fumigatus повышает риск тяжелой астмы почти в три раза (OR=2,98), что подчеркивает клиническую важность выявления этого аллергена.
Медицинские аспекты воздействия плесени: современные рекомендации
Несмотря на значительную распространенность сенсибилизации к плесневым грибам, количество научных публикаций, посвященных этой проблеме, остается ограниченным. Одна из фундаментальных работ – публикация Julia Hurraß с соавторами в Deutsches Ärzteblatt International (2024, DOI: 10.3238/arztebl.m2024.0018) – посвящена медицинским аспектам воздействия плесени в помещениях.
Главная цель этой работы – предоставить врачам алгоритм клинической оценки здоровья пациентов, подвергшихся воздействию плесени, на основе актуальных рекомендаций и эпидемиологических данных. По определению авторов, плесень – это условный термин для микроскопических грибов, образующих гифы и споры. В Германии каждое пятое-шестое жилье имеет проблемы с влажностью или плесенью. Основными ее видами являются Aspergillus spp., Penicillium spp., Stachybotrys chartarum, Chaetomium spp. и др.
Группы риска развития грибково-ассоциированных заболеваний
- Иммуносупрессированные пациенты (первичные и вторичные иммунодефициты)
- Пациенты с тяжелым COVID-19, гриппом, муковисцидозом, ХОБЛ
- Пациенты с тяжелой астмой и АБЛА
Молекулярный профиль грибковой сенсибилизации: роль Alt a 1
Важные данные получены из анализа 3349 человек, чувствительных к молекулярным компонентам грибов, которые были протестированы методом ALEX² в 17 регионах Украины в течение 2020–2022 годов. Результаты исследования опубликованы в Frontiers in Allergy (2024) под названием «Fungi-sensitized individuals have unique profiles where Alt a 1 dominates promoting response to grass, ragweed and cat allergens».
Исследование определило компонент Alt a 1 (Alternaria alternata) как главный триггер среди грибковых аллергенов:
- 79,3% все обследованные имели сенсибилизацию к Alt a 1
- В 62% случаев Alt a 1 был единственным выявленным грибковым аллергеном
Особенно важно, что 84,8% пациентов были полисенсибилизированы и имели уникальные аллергологические профили (от 2 до нескольких десятков молекул). Чаще всего дополнительно наблюдалась чувствительность к травам (Phl p 2), амброзии (Amb a, Amb a 1), кошачьему аллергену (Fel d 1) и криптомерии (Cry j 1).
У детей (77,8% из обследованных) значительно чаще встречалась комбинация Alt a 1 + Phl p 2 (83,2% из всех таких случаев). Использование метода ALEX² позволило оценить важную взаимосвязь между сенсибилизацией к плесени и риском возникновения другой сенсибилизации. Моделирование с помощью байесовского подхода показало, что Alt a 1 повышает вероятность сенсибилизации к Phl p 2. Молекула Alt a 1 определена как «родительский узел» в графах иерархии сенсибилизации, что свидетельствует о ее ключевой роли в развитии полисенсибилизации.
Ограничения традиционной диагностики аллергии на плесневые грибы
Классический клинический алгоритм диагностики включает медицинский анамнез, физикальное обследование, базовую аллергодиагностику (кожные тесты, определение sIgE, sIgG) и, при необходимости, микробиологические, серологические, радиологические методы (которые назначаются только при подозрении на инвазивную инфекцию).
Традиционная диагностика, основанная на использовании экстрактов грибов для кожных прик-тестов и определения sIgE, имеет существенные ограничения из-за вариабельности состава аллергенов и низкой специфичности. Это связано со следующими факторами:
- Экстракты содержат смесь многих антигенов, в том числе перекрестно-реактивных
- Высокая изменчивость состава в зависимости от условий культивирования
- Возможны ложноположительные результаты при сенсибилизации к родственным аллергенам
- Не все клинически значимые молекулы входят в состав экстрактов
В этом контексте современная молекулярная аллергодиагностика открывает новые возможности для персонализированного подхода к пациенту. Учитывая, что по данным литературы большинство пациентов с аллергическими заболеваниями и сенсибилизацией к плесени имеют полисенсибилизацию, ALEX² становится оптимальным диагностическим вариантом.
Возможности компонентной аллергодиагностики: молекулярные характеристики грибковых аллергенов
Грибковые аллергены можно отличить от других источников аллергенов (пыльца, перхоть животных) по типичным семействам белков, в частности по субтилизиноподобным сериновым протеазам. Они охарактеризованы преимущественно как основные аллергены, но, к сожалению, эти аллергены пока недоступны для рутинной диагностики.
Основные семейства грибковых аллергенов
Циклофилины (грибковые изомеразы) включают 5 пептидил-пролил-цис-транс-изомераз и 1 триозофосфат-изомеразу. Белки семейства циклофилинов были идентифицированы как аллергены в плесени и пыльце.
Энолазы – семейство белков Allfam, которое в настоящее время насчитывает 12 аллергенов: 6 из них идентифицированы в плесени, 4 – в рыбе, 1 – в латексе и один – в курице. Описаны перекрестные реакции между энолазами Alt a 6, Cla h 6 и Hev b 9. Распространенность сенсибилизации к грибковым энолазам составляет около 14–30% у лиц, сенсибилизированных к плесени.
Дегидрогеназы – пероксисомальные мембранные белки, принадлежащие к семейству редоксинных аллергенов. Перекрестно реактивные эпитопы были описаны для Asp f 3 и пероксисомального мембранного белка в Candida boidinii. Asp f 3 продемонстрировал высокий потенциал связывания sIgE (49–72%) у лиц, сенсибилизированных к Aspergillus, и полезен для диагностической дифференциации между астмой и АБЛА.
Для диагностической дифференциации между астмой и АБЛА также важно определять молекулу Asp f 6 (*супероксиддисмутаза (MnSOD)) из Aspergillus fumigatus.
Alt a 1: ключевая молекула грибковой аллергии
Ключевой молекулой среди аллергенов плесени является Alt a 1 – основной аллерген Alternaria alternata с распространенностью сенсибилизации более 90%. Этот белок образован как димер кислого гликопротеина без известной биохимической функции, с уникальной структурой димерного белка, похожей на бабочку, которая была обнаружена исключительно среди белков плесени.
Среди пациентов, чувствительных к Alternaria alternata, 92% сообщили об аллергическом рините и 64,2% – об астме. Таким образом, сенсибилизация к Alt a 1 тесно связана с астмой и повышением приема лекарств от астмы. Молекула Alt a 1 считается маркером истинной сенсибилизации, а наличие sIgE к Alt a 1 связано с риском тяжелого течения астмы и является основным критерием для проведения аллерген-иммунной терапии (АИТ) против Alternaria.
ALEX²: преимущества мультиплексной молекулярной диагностики
Для уточнения анамнеза аллергии, ассоциированной с плесенью, и определения стратегии лечения рекомендуется серологическое определение специфических IgE. Наиболее эффективным методом, с помощью которого можно обеспечить высокую специфичность (истинная vs перекрестная сенсибилизация), прогностическую ценность, персонализировать терапию и определить целесообразность АИТ, а также снизить количество необоснованных назначений лекарств, является ALEX².
Таблица 2. Аллергены плесени и дрожжей в ALEX² и их клиническое значение
|
Компонент |
Источник |
Клиническое значение |
|
Alt a 1 |
Alternaria alternata |
Главный маркер истинной сенсибилизации; связан с риском тяжелой астмы и обострений |
|
Alt a 6 (энолаза) |
Alternaria alternata |
Пан-аллерген; вызывает перекрестные реакции с другими грибами и дрожжами |
|
Asp f 1 |
Aspergillus fumigatus |
Маркер истинной сенсибилизации к Aspergillus; важен для диагностики АБЛА |
|
Asp f 3 |
Aspergillus fumigatus |
Пероксисомальный белок; может участвовать в перекрестных реакциях; полезен для дифференциации астмы и АБЛА |
|
Asp f 4 |
Aspergillus fumigatus |
Дополнительный маркер при диагностике АБЛА |
|
Asp f 6* |
Aspergillus fumigatus |
Ассоциирован с более тяжелым течением АБЛА и астмы; перекрестная реактивность |
|
Cla h 8 |
Cladosporium herbarum |
Пан-аллерген; может коррелировать с тяжелым течением ринита и астмы |
|
Mala s 5 |
Malassezia sympodialis |
Связан с атопическим дерматитом, особенно у детей и подростков |
|
Mala s 6 (циклофилин) |
Malassezia sympodialis |
Пан-аллерген; участвует в перекрестных реакциях, усиливает течение АД |
|
Mala s 11* |
Malassezia sympodialis |
Важный маркер тяжелого, рецидивирующего течения атопического дерматита |
|
Penicillium chrysogenum (экстракт) |
Penicillium chrysogenum |
Клиническое значение менее изучено; часто часть полисенсибилизации |
*Mn-супероксиддисмутаза
Преимущества исследования ALEX² в диагностике грибковой сенсибилизации
1. Высокая специфичность
Определяет IgE к отдельным молекулам (Alt a 1, Asp f 6, Mala s 11 и т. д.), а не только к экстрактам. Позволяет отличить истинную сенсибилизацию от перекрестных реакций между различными грибами или другими источниками (например, энолазы, супероксиддисмутазы).
2. Широкий спектр аллергенов
Панель включает экстракты и молекулярные компоненты грибов и дрожжей (Alternaria, Aspergillus, Cladosporium, Penicillium, Malassezia, Candida). Дает возможность одновременно оценить полный профиль сенсибилизации пациента.
3. Клиническая значимость
Выявление именно молекулярных маркеров позволяет прогнозировать клинические последствия сенсибилизации и оптимизировать терапевтический подход.
4. Надежность и снижение ложноположительных результатов
Использование CCD-ингибиторов уменьшает влияние перекрестных углеводных детерминант (частая проблема при грибковой аллергии). Это делает результаты более чистыми и интерпретируемыми.
5. Эффективность для врача и пациента
Требуется всего 100 мкл сыворотки для анализа более 295 аллергенов (178 молекул + 117 экстрактов). Получается единый отчет, удобный для объяснения пациенту и принятия клинических решений.
6. Практические преимущества
Позволяет избежать многократных тестов и снизить общие затраты на обследование. Используется в международных исследованиях, что повышает научное и практическое доверие к методу.
Висновки
- Сенсибилизация к плесневым грибам и дрожжам является распространенной и клинически значимой проблемой, ассоциирующейся с аллергическими заболеваниями (астмой, ринитом) и тяжелыми состояниями (АБЛА, гиперчувствительный пневмонит).
- Классическая диагностика, основанная на кожных тестах и определении IgE к экстрактам, имеет существенные ограничения из-за низкой специфичности и вариабельности состава аллергенов.
- Молекулярная аллергодиагностика, в частности метод ALEX², обеспечивает высокую специфичность, позволяет отличить истинную сенсибилизацию от перекрестных реакций и оценить клиническую значимость выявленных аллергенов.
- Выявление ключевых молекул (Alt a 1, Asp f 6, Mala s 11 и т.д.) с помощью ALEX² позволяет прогнозировать течение болезни, оптимизировать терапию, определить целесообразность аллерген-иммунной терапии и персонализировать подход к пациенту.
- Использование ALEX² в клинической практике повышает эффективность диагностики, снижает количество ложноположительных результатов и облегчает принятие обоснованных клинических решений, что особенно важно у пациентов с полисенсибилизацией.
Литература
- Dramburg S, Hilger C, Santos AF, de las Vecillas L, Hoffmann-Sommergruber K, et al. EAACI Molecular Allergology User's Guide 2.0. Pediatric Allergy and Immunology. 2023;34(S28):e13854. doi:10.1111/pai.13854
- Hilger C, Dramburg S, Santos AF, de las Vecillas L, Hoffmann-Sommergruber K, et al. The Molecular Allergology User's Guide 2.0: Update on relevant new content. Allergo Journal Int. 2023;32(Suppl). doi:10.1007/s40629-023-00260-x
- Twaroch TE, Gunawardana N, Zieglmayer R, et al. Mold Allergens in Respiratory Allergy: From Structure to Therapy. Frontiers in Immunology. 2015.
- Denning DW, O'Driscoll BR, Hogaboam CM, Bowyer P, Niven RM. The link between fungi and severe asthma: a summary of the evidence. European Respiratory Journal. 2006;27(3):615-626. doi:10.1183/09031936.06.00030405
- Abel-Fernández E, Ugalde C, et al. Going over Fungal Allergy: Alternaria alternata and Its Allergens. J Fungi (Basel). 2023;9(5):582. doi:10.3390/jof9050582
- Prester Lj. Dust-borne Asp f 1 and Alt a 1. Arh Hig Rada Toksikol. 2011;62:371-380.
- Muthu V, Sehgal IS, Prasad KT, et al. Utility of recombinant Aspergillus fumigatus antigens in the diagnosis of ABPA: a systematic review and meta-analysis. Clin Exp Allergy. 2018;48:1107-1136.
- Agarwal R, Chakrabarti A, et al. Allergic bronchopulmonary aspergillosis – review of current concepts. International Journal of Mycology & Respiratory Medicine. 2020.
- Stevens DA, Moss RB, Kurup VP, et al. Allergic Bronchopulmonary Aspergillosis in Cystic Fibrosis: serologic studies of Asp f 4 and Asp f 6. Clin Infect Dis. 2003;37(Suppl 3):S225-S231.
- Joest M, et al. Allergic bronchopulmonary aspergillosis in an atopic patient: use of IgE antibodies to Asp f 2, f 4, f 6 in diagnosis. Marcus Joest Case Report. 2021.
- Barbosa D, Diaz-Perales A, Escribese MM, et al. Molecular allergology and its impact in specific allergy diagnosis and therapy. Allergy. 2021;76(12):3642-3658.
- Salo PM, et al. Quantitation of Alternaria and Aspergillus allergens in commercial products and dust samples. J Allergy Clin Immunol.
- Prester Lj, Macan J. Determination of Alt a 1 in poultry farms and a sawmill using ELISA. Medical Mycology. 2010;48:298-301.
- EAACI Molecular Allergology User's Guide 2.0. Available at: https://eaaci-cdn-vod02-prod.azureedge.net